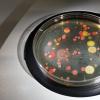

您的位置:首页 > Tags >菌株

一些维京人可能已经死于人类最致命的病原体之一的现在灭绝的菌株:Smallpox。研究人员在维京时代北欧遗骸中收集了病毒中

仅现代医院和抗生素治疗并不能产生我们今天看到的所有对细菌具有抗药性的菌株。相反,新的研究发现,在抗生素广泛使用之前的选择
培养先前“不耐药”细菌的新方法。文化依赖的研究允许突出大量的大量佩戴物和先前未报告的细菌菌株从塔纳纳斯沙漠中脱颖而出。微

附着在细菌细胞壁上的多个噬菌体的假色透射电子显微照片。一种新的遗传方法可以加快对噬菌体-微生物相互作用的研究,从而对健康

研究人员发现一种方法来创造和控制氧空隙层在氮氧化物晶体中的氧空位层的方向和周期,低至60℃。°机会发现导致一个简

从弗莱明的冷冻样品中长出霉菌。研究人员首次对亚历山大·弗莱明(Alexander Fleming)青霉素霉菌的基因组进行

夏威夷短尾鱿鱼。已经确定了两个控制鱿鱼发光器官中栖息的发光细菌所需的关键基因表达的关键遗传基因,以杀死竞争性细菌细胞。已

代表物种共存的抽象艺术。来自Amolf(阿姆斯特丹,荷兰)和哈佛大学(美国)的研究人员展示了有机体如何移动的能力如何在稳

宇航员迈克尔泡沫采样来自国际空间站的饮用水输送系统。可能在起飞前殖民分配器的微生物仍然易于抗生素。国际空间站的细菌比地基

UNSW的研究人员呼吁新的咳嗽疫苗来打击能够逃避疫苗产生的免疫以及身体自己的防御的甜味菌株的出现。根据UNSW的研究人员
图文推荐

2022-06-11 09:58:03

2022-06-11 09:02:14

2022-06-11 08:58:03

2022-06-10 18:01:01

2022-06-10 17:58:03

2022-06-10 16:58:03
热点排行
精彩文章

2022-06-11 09:58:06

2022-06-11 08:58:06

2022-06-10 19:58:04

2022-06-10 18:58:04

2022-06-10 17:58:05

2022-06-10 15:58:04
热门推荐
